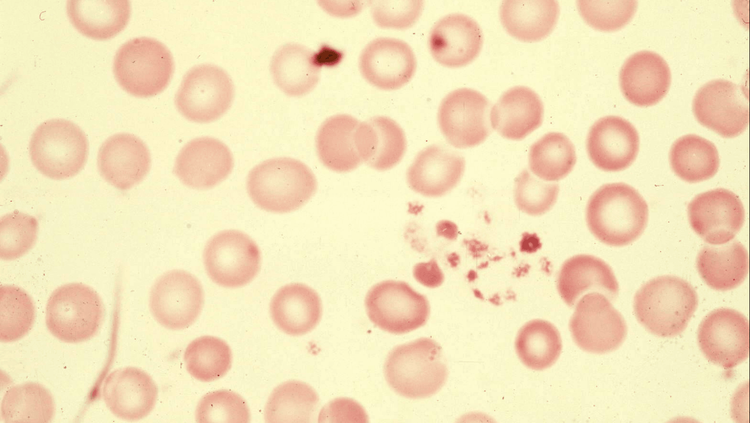
तीव्र ताप ? मळमळ? अंगदुखी ? लवकरात लवकर डॉक्टर कडे जाऊन रक्त तपासणी करून घेणे

गडगडाट करत धोधो कोसळणारा आषाढातला पाऊस -अचानक येणार्या -जाणार्या श्रावण सरी आणि भाद्रपदातला सरता पाऊस असा एकूणच पाऊस म्हणजे ज्याम रोमँटीक मौसम असतो. पण याच प्रेमाच्या ऋतूत योग्य काळजी नाही घेतली तर डेंग्यूसारखे आजार कधी आपल्याला झपाटून टाकतील याची खात्री देता येत नाही.दरवर्षी,पावसाळ्यात अंदाजे ४० कोटी लोकांना डेंग्यूच्या विषाणूची लागण होते.वर्षानुवर्षं आपल्याला त्रस्त करणारा हा छळवादी आजार आहे तरी काय ते आज समजून घेऊ या !!
डेंग्यू:अंदाजे ४० कोटी लोकांना पछाडणार्या रोगापासून सावध रहा!


डेंग्यू तापाची लक्षणे
डेंग्यू हा विषाणूजन्य आजार आहे. डेंग्यूचा विषाणू हा एडिस इजिप्ती नावाच्या डासांमार्फत पसरतो. साधारणतः हे डास दिवसा चावणारे असतात.मादी एडिस डास चावल्यानंतर सुमारे ५ दिवसांत डेंग्यू तापाची लक्षणे दिसू शकतात. यासोबतच हा आजार शरीरात होण्याचा कालावधी ३ दिवसांपासून ते ३० दिवसांचा असू शकतो.
ह्या डासांची उत्पत्ती मुख्यत्वे साठलेल्या पाण्यात होते. डेंग्यू झालेल्या रुग्णाला चावलेला डास जर निरोगी माणसाला चावला तर निरोगी माणसाला पण डेंग्यूची लागण होते.डासानी चावा घेतल्यानंतर तीव्र ताप, डोकेदुखी, अंगदुखी, अशक्तपणा, उलट्या होणे, त्वचेवर लाल व्रण उठणे ही सर्वसाधारण लक्षणं पाच ते सात दिवसांमध्ये दिसू लागतात.कधी कधी उचक्या लागणे, तळहात-पायांना खाज येणे, भूक कमी लागणे किंवा मळमळणे, नाकातून रक्त येणे इत्यादी लक्षणं दिसून येऊ शकतात.
तीव्र ताप ? मळमळ? अंगदुखी ? लवकरात लवकर डॉक्टर कडे जाऊन रक्त तपासणी करून घेणे
डेंग्यूचा आजार शरीरातील सर्वच अवयवांवर परिणाम करतो. बरेचदा त्यातूनच गुंतागुंत होऊन तो गंभीर रूप घेऊ शकतो. हृदयविकार, मधुमेह, मूत्रपिंड, यकृताचा आजार असणाऱ्या रुग्णांमध्ये मुळातच रोगप्रतिकारक शक्ती कमी असल्यामुळे गुंतागुंत होण्याचे प्रमाण वाढते.
डेंग्यूचा ताप साधारणपणे आजारपणाच्या तिसऱ्या ते सातव्या दिवशी कमी होतो. त्यानंतर अत्यंत थकवा जाणवतो, जो काही दिवस ते आठवडे टिकू शकतो. रुग्णाच्या प्लेटलेट आणि ल्युकोसाइट (पांढर्या रक्तपेशी) मध्ये झपाट्याने घट होते. काही प्रकरणांमध्ये, गंभीर अवयवांची कार्यक्षमता कमी होते आणि अंतर्गत रक्तस्त्राव होऊ शकतो.
तीव्र ताप, मळमळ, अंगदुखी होत असल्यास लवकरात लवकर डॉक्टर कडे जाऊन रक्त तपासणी करून घेणे शहाणपणाचे आहे. बहुतांश वेळा डॉक्टरांना डेंग्यूचा संशय असल्यास ते संपूर्ण रक्त गणना (प्लेटलेटच्या संख्येसह) करण्याची शिफारस करतात. ह्या चाचणी मध्ये प्लेटलेट्स संख्या कमी वाटल्यास डॉक्टर डेंग्यूच्या इतर काही चाचण्या करण्यास सांगतात.प्लेटलेटची संख्या साधारणपणे आजाराच्या४ व्या दिवशी लक्षणीयरीत्या कमी होते . प्रौढांमध्ये आजाराच्या 3 व्या दिवसापासून ते 7 व्या दिवसापर्यंत प्लेटलेटची संख्या थोडीशी कमी होते आणि ८ किंवा ९ व्या दिवसापर्यंत सामान्य होते.

'एडिस इजिप्ती' डासांची उत्पत्ती थांबविणे हा डेंग्यू रोखण्याचा सर्वात मोठा प्रतिबंधात्मक उपाय आहे.
पाण्याचा पिंप व टाक्या नियमित साफ करणे, सांडपाण्याचा निचरा व्यवस्थित करणे, फ्लॉवर पॉट, झाड्यांच्या कुंड्या इत्यादींमध्ये पाणी साठू न देणे, घरात व बाथरुममध्ये घरगुती कीटकनाशकांची नियमित फवारणी करणे, घर आणि आजूबाजूचा परिसर स्वच्छ ठेवणे, साठवलेले उघडे पाणी ताबडतोब रिकामे करणे, घरात किंवा परिसरात कमळासाठीच्या हौदामध्ये गप्पी मासे पाळणे असे प्राथमिक उपाय आहेत.
डेंग्यूचे डास सकाळी आणि संध्याकाळी जास्त सक्रिय असतात. त्यामुळे या वेळी बाहेर जाणे टाळावे. शक्यतो त्वचा झाकून ठेवावी. त्वचेवर डास प्रतिरोधक औषधं लावावेत.त्याबरोबरच, आहारात ऋतूप्रमाणे योग्य बदल करावेत. रुग्णाला सकस आणि घरगुती आहार द्यावा. उलट्या, जुलाब होत असल्यास फळांचा रस द्यावा. 'किवी' आणि 'ड्रॅगन फ्रूट' आणि इतरही फळे रक्त वाढवण्यास मदत करतात. डॉक्टरांनी दिलेल्या औषधांसोबतच काही आयुर्वेदिक औषधे जसे पपईच्या पानांच्या रस डॉक्टरांच्या सल्ल्याने देता येईल.
शेवटचे पण महत्त्वाचे, रुग्णाला प्रसन्न वाटेल असे वातावरण द्यावे. नियमित व्यायाम, सूर्यनमस्कार आणि सोबत प्रियजनांना सहवासही मनाला उभारी देईल ज्यामुळे आरोग्य सुधारण्यास मदत होईल.
लेखिका :पद्मिनी ढवळे.
व्यवसायाने संगणक अभियंता आहेत.